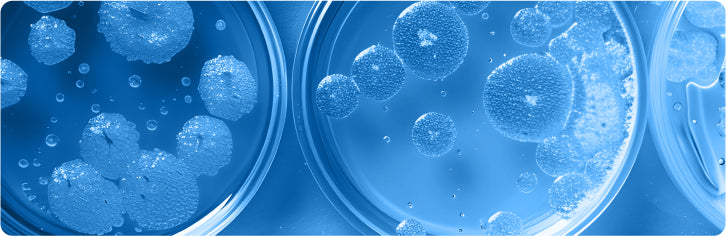

Collection:
Cell Culture
At Innovative Research, we know the importance of high-quality, reliable products for your research. Our extensive cell culture range includes human serums, animal serums, and proteins. Browse our cell culture additives catalog and find the one that matches the type, price, or attributes you need.
-
Pooled Human AB Serum Plasma Derived Heat Inactivated
SKU: ISERABHI100MLRegular price $202.00Sale price $202.00 Regular priceUnit price / per -
Pooled Human AB Serum Plasma Derived
SKU: ISERAB100MLRegular price $192.00Sale price $192.00 Regular priceUnit price / per -
Viral Transport Medium
SKU: IGVTM500MLRegular price From $178.00Sale price From $178.00 Regular priceUnit price / per -
Viral Transport Medium Liquid Amies
SKU: IGVTMA500MLRegular price From $86.00Sale price From $86.00 Regular priceUnit price / per -
Pooled Human AB Serum Off The Clot Heat Inactivated
SKU: ISERABOTCHI100MLRegular price $540.00Sale price $540.00 Regular priceUnit price / per -
MCF 10A Cell Lines Complete Growth Medium
SKU: IMCF10ACLCGM500MLRegular price $174.00Sale price $174.00 Regular priceUnit price / per -
Pooled Human AB Serum Off The Clot
SKU: ISERABOTC100MLRegular price $540.00Sale price $540.00 Regular priceUnit price / per -
Innovative Grade US Origin Fetal Bovine Serum Heat Inactivated
SKU: IGFBSERHI25MLRegular price From $108.00Sale price From $108.00 Regular priceUnit price / per -
Hams F-12 Without Phenol Red
SKU: IHAMSF120813500MLRegular price $37.00Sale price $37.00 Regular priceUnit price / per -
Hams F-12K Without Phenol Red
SKU: IHAMSF12K0913500MLRegular price $42.00Sale price $42.00 Regular priceUnit price / per -
McCoys 5A Without Phenol Red
SKU: IMCCOYS5A0714500MLRegular price $37.00Sale price $37.00 Regular priceUnit price / per -
IMDM Glucose Free
SKU: IIMDM0516500MLRegular price $32.00Sale price $32.00 Regular priceUnit price / per -
Innovative Grade US Origin Fetal Bovine Serum
SKU: IGFBSER25MLRegular price From $108.00Sale price From $108.00 Regular priceUnit price / per -
DMEM High Glucose Without Phenol Red
SKU: IDMEM0223500MLRegular price $21.00Sale price $21.00 Regular priceUnit price / per -
DMEM/F12 Glucose Free
SKU: IDMEMF120322500MLRegular price $21.00Sale price $21.00 Regular priceUnit price / per
The latest in science and research
-
Product References
Breakthrough ELISA & CLIA Kits from Innovative Research
By Adam Awdish On Aug 16, 2024At Innovative Research, we're committed to providing cutting-edge tools that empower your scientific discoveries. Our premium selection of human immunoassay...
-
Product References
In Stock Alert: Human and Animal-sourced tPA
By Wendy Wise On Jun 05, 2024Understanding Human Tissue Plasminogen Activator (tPA) tPA is an essential enzyme in the body that helps break down blood clots...
-
Product References
Trending ELISA Kits, Designed with You in Mind - Order Now While Supplies Last
By Adam Awdish On May 22, 2024We currently have overstock of some of our current most popular ELISA Kits, including coagulation factor kits, IgG, tPA, and...
Explore other categories
1
/
of
7